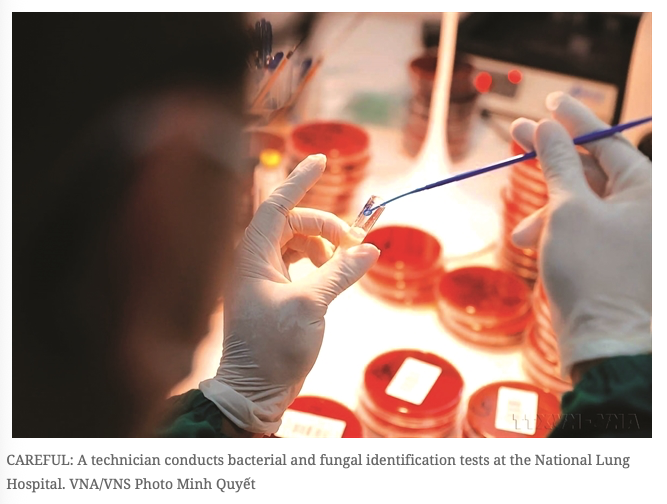

การป้องกันโรคเพื่อเวียดนามที่มีสุขภาพดี
ปีนี้ถือเป็นการเฉลิมฉลองวันสุขภาพแห่งชาติครั้งแรก ภายใต้หัวข้อ "การป้องกันโรคเชิงรุกเพื่อเวียดนามที่มีสุขภาพดี"

ด้วยการกําหนดให้วันที่ 7 เมษายนเป็นวันสุขภาพแห่งชาติ เวียดนามกําลังแถลงอย่างชัดเจน: อนาคตของประเทศจะไม่เพียงสร้างขึ้นจากการเติบโตทางเศรษฐกิจเท่านั้น แต่ยังสร้างขึ้นจากความเป็นอยู่ที่ดีของประชาชนอีกด้วย
มันทําเครื่องหมายการเปลี่ยนแปลงเชิงกลยุทธ์ที่สําคัญ — จากความคิดการรักษาก่อนไปสู่ความคิดที่การป้องกันเป็นรากฐาน แนวทางระยะยาว และหลักการชี้นํา — การวางสุขภาพของผู้คนมากกว่า 100 ล้านคนเป็นศูนย์กลางของนโยบายการพัฒนาทั้งหมด



ปัจจุบันเวียดนามกําลังเผชิญกับความท้าทายมากมาย รวมถึงการเพิ่มขึ้นของโรคไม่ติดต่อ ประชากรสูงอายุ การเปลี่ยนแปลงสภาพภูมิอากาศ ความเสี่ยงของการแพร่ระบาดที่เกิดขึ้นใหม่ และปัญหาด้านสุขภาพจิตและโภชนาการ
ปีนี้ถือเป็นการเฉลิมฉลองวันสุขภาพแห่งชาติครั้งแรก ภายใต้หัวข้อ "การป้องกันโรคเชิงรุกเพื่อเวียดนามที่มีสุขภาพดี"
ที่มา vietnamnews.vn
วันที่ 10 เมษายน 2569






